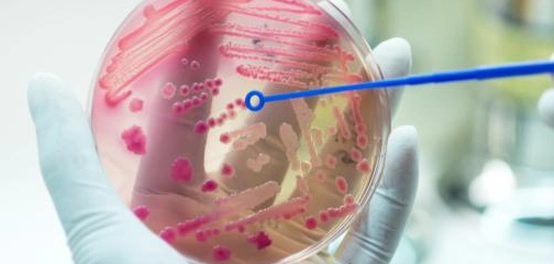

نظرة عامة حول مرض تسمم الدم عند الأطفال
يُعتبر تسمم الدم، أو ما يعرف بالإنتان، رد فعل الجسم تجاه عدوى بكتيرية أو فيروسية أو فطرية. هذه العدوى قد تكون في أي مكان في الجسم، مثل المسالك البولية، أو الرئتين (الالتهاب الرئوي)، أو الجلد، أو العظام، أو حتى في الدماغ (التهاب السحايا). وعلى الرغم من أنّه من الممكن أن يصيب الأفراد في أي مرحلة عمرية، إلا أن الأطفال، وخاصة حديثي الولادة والرضع، هم الأكثر عرضة للإصابة به.
في حالة عدم تلقي العلاج المناسب في الوقت المحدد، قد يؤدي تسمم الدم إلى تلف دائم في الأنسجة، وفشل في وظائف الأعضاء الحيوية، وفي الحالات الشديدة، قد يتسبب في الوفاة. يُطلق على تسمم الدم الذي يصيب الرضع خلال الأشهر الثلاثة الأولى من حياتهم اسم “إنتان الرضع”.
الكشف عن علامات وأعراض تسمم الدم لدى الأطفال
تتشابه أعراض تسمم الدم في بدايتها مع الأعراض الشائعة للعدوى، مثل ارتفاع درجة الحرارة (الحمى)، والسعال، والإسهال. ومع ذلك، توجد علامات أخرى يجب الانتباه إليها، والتي قد تشير إلى تطور الحالة نحو تسمم الدم:
- تسارع ملحوظ في ضربات القلب.
- زيادة في سرعة التنفس.
- انخفاض ملحوظ في ضغط الدم.
- برودة غير طبيعية في الجلد.
- الشعور بنعاس شديد وتعب غير معتاد.
- حالة من الارتباك وعدم التركيز.
طرق ووسائل تشخيص الإصابة بتسمم الدم لدى الأطفال
يعتمد تشخيص تسمم الدم في البداية على قياس العلامات الحيوية للطفل، مثل درجة حرارة الجسم، ومعدل ضربات القلب، وسرعة التنفس. بالإضافة إلى ذلك، قد يطلب الطبيب إجراء بعض الفحوصات المخبرية والإشعاعية لتأكيد التشخيص وتحديد مصدر العدوى. تشمل هذه الفحوصات:
- تحليل البول أو البراز للكشف عن وجود عدوى.
- أخذ عينة من الأنسجة، أو الجلد، أو السوائل من المنطقة المصابة وفحصها مجهرياً.
- أخذ عينة من اللعاب، أو البلغم، أو المخاط لتحليلها.
- قياس ضغط الدم بشكل دوري.
- التصوير بالأشعة السينية، أو التصوير بالموجات فوق الصوتية، أو التصوير المقطعي المحوسب (CT scan) لتحديد مكان العدوى وتقييم مدى انتشارها.
استراتيجيات علاج تسمم الدم عند الأطفال
يتم علاج تسمم الدم في المستشفى، حيث يتمكن الأطباء من مراقبة حالة المريض عن كثب وتقديم الرعاية اللازمة. في بعض الحالات، قد يحتاج الطفل إلى الدخول إلى وحدة العناية المركزة للأطفال (PICU) لمراقبة وظائف الأعضاء الحيوية بشكل أفضل. تشمل الخيارات العلاجية الرئيسية ما يلي:
- المضادات الحيوية: يتم إعطاء المضادات الحيوية عن طريق الوريد للقضاء على العدوى المسببة لتسمم الدم.
- السوائل وأدوية ضغط الدم: يتم إعطاء السوائل عن طريق الوريد لتعويض السوائل المفقودة والحفاظ على ضغط الدم. قد يتم أيضًا إعطاء أدوية لرفع ضغط الدم وتحسين وظائف القلب.
- إجراءات أخرى: في بعض الحالات، قد يحتاج المريض إلى نقل دم، أو تزويده بالأكسجين إذا كان يعاني من صعوبة في التنفس. في حالة حدوث تلف في الكلى وتوقفها عن إنتاج البول، قد يلجأ الطبيب إلى الغسيل الكلوي (Dialysis) لتنقية الدم.
المضاعفات المحتملة لتسمم الدم
يمكن أن يؤدي تسمم الدم إلى مضاعفات خطيرة إذا لم يتم علاجه بسرعة. قد تشمل هذه المضاعفات تلف الأعضاء، وفشل الأعضاء، والصدمة الإنتانية، وحتى الوفاة.
سبل الوقاية من تسمم الدم
الوقاية من العدوى هي أفضل طريقة لمنع تسمم الدم. يمكن تحقيق ذلك من خلال:
- الحصول على التطعيمات الموصى بها.
- غسل اليدين بانتظام.
- الحفاظ على نظافة الجروح.
- التماس العناية الطبية الفورية عند ظهور علامات العدوى.